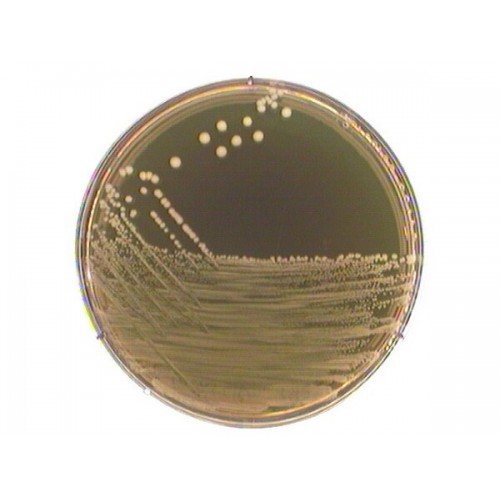

M 17 AGAR SEG. TERZAGHI 500GR MERCK
Modelo: 1151080500
-
R$1.581,06
ou até 3x de R$527,02 sem juros
Economize 5% no PIX: R$1.502,01
ou 3.5% no boleto: R$1.525,72
Descrição
M 17 AGAR SEG TERZAGHI MERCK
RENDIMENTO 55,0g/l P/STREPTOCOCCI NO LEITE
EMBALAGEM 500GR
Mode of Action
Addition of sodium b-glycerophosphate increases the buffering capacity of the medium; this promotes the growth of lactic streptococci and the development of large bacteriophage plaques.
Typical Composition (g/litre)
Peptone from soymeal 5.0; peptone from meat 2.5; peptone from casein 2.5; yeast extract 2.5, meat extract 5.0; lactose monohydrate 5.0; ascorbic acid 0.5; sodium b-glycerophosphate 19.0; magnesium sulfate 0.25; agar-agar 12.75.
Preparation
Suspend 55 g M 17 agar/litre, autoclave (15 min at 121 °C).
pH: 7.2 ± 0.2 at 25 °C.
The prepared media are clear and brown.
Prepared plates can be stored in the refrigerator (approx. 6-8 °C) for up to 10 days.
RENDIMENTO 55,0g/l P/STREPTOCOCCI NO LEITE
EMBALAGEM 500GR
Mode of Action
Addition of sodium b-glycerophosphate increases the buffering capacity of the medium; this promotes the growth of lactic streptococci and the development of large bacteriophage plaques.
Typical Composition (g/litre)
Peptone from soymeal 5.0; peptone from meat 2.5; peptone from casein 2.5; yeast extract 2.5, meat extract 5.0; lactose monohydrate 5.0; ascorbic acid 0.5; sodium b-glycerophosphate 19.0; magnesium sulfate 0.25; agar-agar 12.75.
Preparation
Suspend 55 g M 17 agar/litre, autoclave (15 min at 121 °C).
pH: 7.2 ± 0.2 at 25 °C.
The prepared media are clear and brown.
Prepared plates can be stored in the refrigerator (approx. 6-8 °C) for up to 10 days.